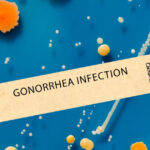
cazurile de gonoree si sifilis au atins un nivel record in europa in mai putin de zece ani infectiile s au triplat 67c4dac4bbe07

Declarațiile lui Zelenski după summitul de la Londra
Președintele ucrainean Volodimir Zelenski a oferit primele sale declarații după discuțiile desfășurate la Londra. El a subliniat că simte un sprijin puternic pentru Ucraina și poporul ucrainean, conform informațiilor furnizate de BBC. În cadrul unei conferințe de presă, Zelenski a fost întrebat despre călătoria sa la Casa Albă, unde a discutat despre complexitatea negocierilor sensibile în public. El a afirmat că „nu a fost corect” ca astfel de discuții să se desfășoare complet deschis, având în vedere că „dușmanii pot profita” de neînțelegerile dintre aliați.
Referitor la disputa cu președintele american Donald Trump, Zelenski a declarat că nu vrea să se concentreze asupra conflictului, ci să treacă la discuții „constructive” despre viitor. „Dacă suntem constructivi, va veni un rezultat pozitiv”, a adăugat el. Întrebat dacă ar fi dispus să reînceapă discuțiile cu Trump, el a explicat că a călătorit la Casa Albă din respect, datorită invitației președintelui american.
Zelenski a subliniat importanța ca poziția ucraineană să fie auzită, reiterând că nu a intenționat niciodată să „insulte” pe nimeni. De asemenea, președintele a menționat că acordul asupra mineralelor este gata pentru semnare, subliniind că acesta va fi semnat dacă părțile sunt pregătite.
În plus, Zelenski a insistat asupra faptului că Rusia este agresorul în conflictul actual și a avertizat că nu ar dori ca războiul să fie prezentat în mod eronat, sugerând că există două părți egale. El a evidențiat unitatea europeană, care a atins un „nivel extrem de înalt”, și a mulțumit tuturor partenerilor și prietenilor pentru sprijinul oferit Ucrainei.
Summitul de la Londra a avut loc după ce liderii europeni s-au unit în jurul lui Zelenski, în urma unei confruntări cu Donald Trump, și a inclus 18 lideri din Europa, Canada și Turcia, care au discutat despre garanțiile de securitate pentru Ucraina. Participanții au convenit asupra patru puncte esențiale pentru sprijinul Ucrainei, inclusiv continuarea ajutorului militar și asigurarea participării Ucrainei la discuțiile despre pace.